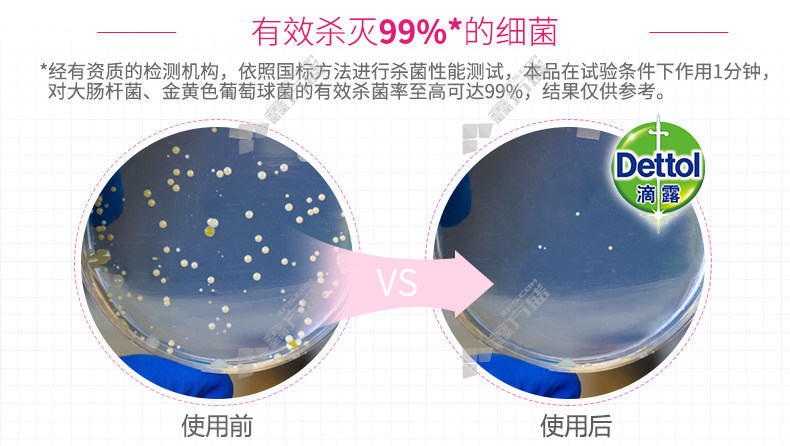

滴露 DETTOL hello kitty卫生湿巾 10抽 200*150mm
品牌:
滴露 DETTOL
DETTOL
最少起订量:
1个
商品编码:
12480941
件装数量:
40包/件
商品规格:
10抽/200*150mm
配送至:
请选择
我们的优势
- 品类丰富 一站购齐
- 阳光采购 价格透明
- 快速响应 售后无忧
- 正品保证 库存充足
温馨提示:
- 购买数量小于现货库存时,可当日出货。
- 购买数量大于现货库存时,请以预计出货日为准。
商品名称:
滴露 DETTOL hello kitty卫生湿巾 10抽 200*150mm
品牌:滴露 DETTOL
件装数量:40包/件
商品规格:10抽/200*150mm
抽数:
10抽
纸张尺寸:
200*150mm
湿纸巾材质:无纺布

三仕达 75%酒精带盖湿巾 80抽 200*150mm
12.60

维达 VW1028 杀菌湿巾 80抽 180*200mm
13.50

心相印 XCA001 卫生湿巾抽 10抽 180*170mm
3.48

维达 VW2004 婴儿手口湿巾 80抽 150*200mm
11.80

心相印 XCB001 洁肤湿巾抽 10抽 200*160mm
3.48

维达 VW2002 温和洁肤婴儿湿巾 80抽 160*200mm
11.60

维达 VW1028 杀菌湿巾 80抽/包 12包/箱 180*200mm
151.00

维达 VW1009 消毒便携式湿巾 10抽/包 60包/箱 180*180mm
155.00

三仕达 带盖婴儿手口柔湿巾 70抽 120*150mm
5.20

三仕达 消毒卫生湿巾 80抽 180*150mm
9.20

三仕达 洁肤卫生湿巾 20抽 150*200mm
3.54

三仕达 干湿两用洁面巾 60节 200*200mm
9.00

海氏海诺 医用酒精消毒棉片 50抽 120*120mm
13.40

利尔康 一次性医用消毒巾 60片/包
19.40

洁柔 JS005 水润净肤湿巾 10片 180*180mm
3.65

洗得宝 75%乙醇消毒湿巾 20抽 145*190mm
7.50

滴露 DETTOL hello kitty卫生湿巾 10抽 200*150mm
5.40

三仕达 翻盖消毒卫生湿巾 20抽 200*180mm
4.83

心相印 XCB010 湿巾 16抽 180*180mm
3.41
JS217-01酒精杀菌卫生湿巾 40抽 200*160mm JS217-01
30.90
















 下载APP
下载APP 中铁微信
中铁微信